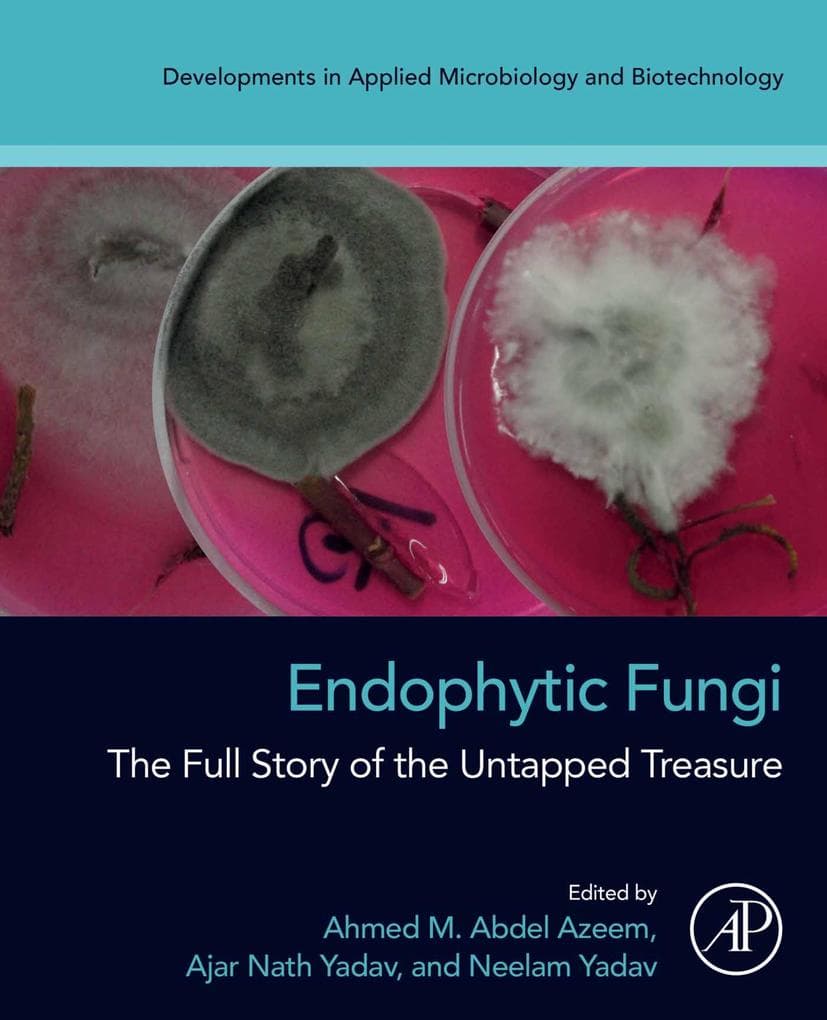
Endophytic Fungi

Postbiotics: Health and Industry provides a detailed overview on the fundamentals, biological and therapeutic properties, safety, and application of postbiotics in health and industry. Sections cover the fundamentals of postbiotics, which include insights on probiotic microorganisms, postbiotics, and host-microbe interaction, analysis, and characterization of postbiotics. The book goes on to delve into the different types of postbiotics and their mechanisms. Remaining sections explore various health, pharmaceutical, and industrial applications of postbiotics.
- Provides an overview on the separation, characterization, and identification of postbiotics from probiotic microbes
- Includes classes of postbiotics and their mechanisms of action
- Discusses the safety of postbiotics in humans and animals and the use of multiomics to understand the effect of postbiotics on human physiology
- Analyzes existing regulatory framework for postbiotics